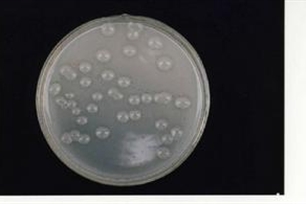
培养基

【培养基】的意思和解释
【培养基】 是什么意思(来源:辞典修订版)
- 以人工方法配制含有各种基本营养成分或某些特殊成分的培养材料。
【培养基】 图片鉴赏
查字典的部份资料来自网络或由网友提供,不保留版权,如有侵权,请与我们联系以从站上删除! 免责声明:本站非营利性站点,以方便网友为主,仅供学习。
Tip:SCCG
